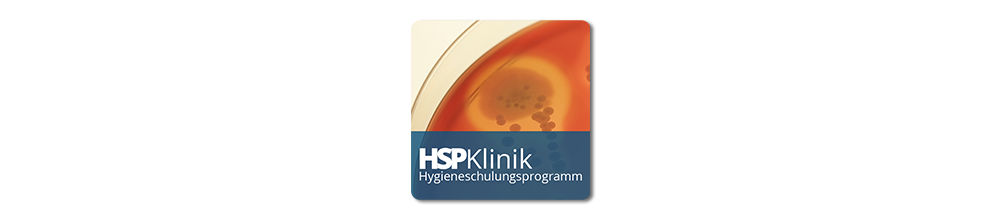

Das Ziel des Arbeitsschutzes ist es, die Sicherheit und die Gesundheit aller Personen zu schützen, die in einem Unternehmen tätig sind. Wie dies im Einzelnen erreicht werden soll, ist in einem komplexen System von Gesetzen und Vorschriften geregelt. Diese Lerneinheit gibt Ihnen einen Überblick darüber, wie das Arbeitsschutzsystem in Deutschland aufgebaut ist.
Hinweis
Hinweis: In diesen Kurs werden Sie automatisch anhand Ihrer Kontaktdaten aus dem Verzeichnisdienst von DIAKOVERE ("Active Directory") eingeschrieben. (Firma = AS | DAH | DAL | DK | DKR | DPF | DS | FS | MVZ) [👉 Wo pflege ich meine Kontaktdaten?]
- Abschnitt 1: Einführung
- Abschnitt 2: Aufbau des Arbeitsschutzsystems in Deutschland
- Abschnitt 3: Arbeitsunfälle
- Abschnitt 4: Die Unfallpyramide
- Abschnitt 5: Schluss

In diesem Kurs lernen Sie, wie Sie einen Brand bekämpfen. So können Sie im Fall eines Feuers schnell richtig handeln und Verletzungen und Schäden vermeiden oder geringhalten.
Hinweis
Hinweis: In diesen Kurs werden Sie automatisch anhand Ihrer Kontaktdaten aus dem Verzeichnisdienst von DIAKOVERE ("Active Directory") eingeschrieben. (Firma = AS | DAH | DAL | DK | DKR | DPF | DS | FS | MVZ) [👉 Wo pflege ich meine Kontaktdaten?]
- Abschnitt 1: Einführung
- Abschnitt 2: Was tun im Brandfall?
- Abschnitt 3: Brände und Feuerlöscher
- Abschnitt 4: Brandschutz
- Abschnitt 5: Schluss

Mit diesem Kurs erwerben Sie Basiswissen im Datenschutz. Dieser Kurs ist verpflichtend für alle Beschäftigten der DIAKOVERE sowie Grundlage und Voraussetzung für den Kurs "Datenschutz Praxis".
Hinweis
Hinweis: In diesen Kurs werden Sie automatisch anhand Ihrer Kontaktdaten aus dem Verzeichnisdienst von DIAKOVERE ("Active Directory") eingeschrieben. (Firma = AS | DAH | DAL | DK | DKR | DPF | DS | FS | MVZ) [👉 Wo pflege ich meine Kontaktdaten?]
- Verarbeitung von Personendaten;
- Rechtliche Einordnung des Datenschutzes;
- Abgrenzung tangierender Gesetze;
- Datenschutzprinzip;
- Auswirkungen von Datenschutzverstößen aus datenschutzrechtlicher und strafrechtlicher Sicht.

Die Durchführung von Maßnahmen der Basishygiene vermeidet Erregerübertragungen und schützt so Ihre Patient*innen und auch Sie selbst. In dieser Lerneinheit lernen Sie die Grundlagen der Erregerübertragung und die Händedesinfektion als wichtigste Maßnahme der Basishygiene kennen.
Hinweis
Hinweis: In diesen Kurs werden Sie automatisch anhand Ihrer Kontaktdaten aus dem Verzeichnisdienst von DIAKOVERE ("Active Directory") eingeschrieben. (Firma = AS | DAH | DAL | DK | DPF | DS | FS | MVZ) [👉 Wo pflege ich meine Kontaktdaten?]
- Abschnitt 1: Einführung
- Abschnitt 2: Die Infektionskette
- Abschnitt 3: Basishygiene
- Abschnitt 4: Händedesinfektion
- Abschnitt 5: Schluss
Mitarbeiter in Krankenhäusern vernachlässigen häufig die Händehygiene, obwohl sie um die erhöhte Gefahr der Ansteckung durch pathogene Erreger oder deren Übertragung über die Hände wissen. Welche Regeln müssen beim Waschen, Desinfizieren und Pflegen der Hände sowie beim Tragen von Einmalhandschuhen eingehalten werden?
Hinweis
Hinweis: In diesen Kurs werden Sie automatisch anhand Ihrer Kontaktdaten aus dem Verzeichnisdienst von DIAKOVERE ("Active Directory") eingeschrieben. (Firma = DKR) [👉 Wo pflege ich meine Kontaktdaten?]
- 01.1 - Die unsichtbare Gefahr
- 01.2 - Händehygiene im Krankenhaus
- 01.3 - Händewaschen und Hautpflege
- 01.4 - Umgang mit Handschuhen

Das Tragen von Arbeitskleidung im Krankenhaus dient einerseits dem eigenen Schutz und zum anderen soll damit die Verbreitung von Mikroorganismen verhindert werden. Im Durchschnitt wird sie täglich acht Stunden getragen und muss während dieser Zeit vielen Anforderungen gerecht werden. Welche Vorgaben bezüglich Umgang und Nutzung sind dabei einzuhalten?
Hinweis
Hinweis: In diesen Kurs werden Sie automatisch anhand Ihrer Kontaktdaten aus dem Verzeichnisdienst von DIAKOVERE ("Active Directory") eingeschrieben. (Firma = DKR) [👉 Wo pflege ich meine Kontaktdaten?]
- 02.1 - Arbeitskleidung für Ärztliches u. Pflegepersonal
- 02.2 - Persönliche Schutzausrüstung